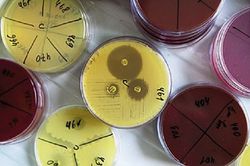

Разработаны тесты для определения устойчивости бактерий к антибиотикам
Количество новых бактерий, которые вызывают трансграничные эпидемии, постоянно возрастает. Исследователи согласны с тем, что не количество бактерий является проблемой, а повышение их устойчивости к антибиотикам.
Работы, посвященные теме резистентности к антибиотикам, были опубликованы в Emerging Infectious diseases и The Journal of Clinical Microbiology.
Некоторые антибиотики, такие как антибиотики цефалоспоринового ряда, должны быть зарезервированы для самых серьезных случаев. Но сейчас эта группа абсолютно неактивна в отношении некоторых бактериальных микроорганизмов и, следовательно, не дает эффективного лечения.
И поэтому медики часто сталкиваются с ситуациями, когда лечение банальной инфекции, например, лечение инфекции мочевых путей или внутрибрюшных инфекций, не имеет никакого эффекта. И это ставит жизнь пациентов под угрозу.
По статистике, каждый год около 25 000 смертей в Европе связано с ростом устойчивости микробов к антибиотикам.
В попытке сдержать эту усиливающуюся устойчивость, исследователи Inserm разработали систему, которая может быстро обнаружить ферменты, ответственные за порождение устойчивости к двум классам антибиотиков широкого спектра действия: цефалоспоринам и карбапенемам. Наличие фермента в анализах указывает на наличие устойчивости микроорганизмов к препаратам этих групп.
В настоящее время эти тесты активны в отношении бактерий, выделенных из биологических образцов. Результат доступен менее чем через 2 часа (в сравнении с 24-72-часовым ожиданием результата в современных методах). Тесты обладают высокой чувствительностью и высоконадежны (100%).
Патрис (Patrice Nordmann) директор отдела исследований Inserm и главный автор данной работы, отмечает: "Эти тесты в настоящее время используются, чтобы определить чувствительность микроорганизмов при работе непосредственно с биологическими средами, такими как кровь или моча".
Применяясь прямо у постели больного, диагностические тесты помогут врачам оптимизировать использование антибиотиков, позволят улучшить лечение инфицированных пациентов, поспособствуют изоляции больных, инфицированных резистентными бактериями, таким образом, не допустив развития эпидемии в больницах.
Опубликовано: webapteka.by 16 октября 2012






